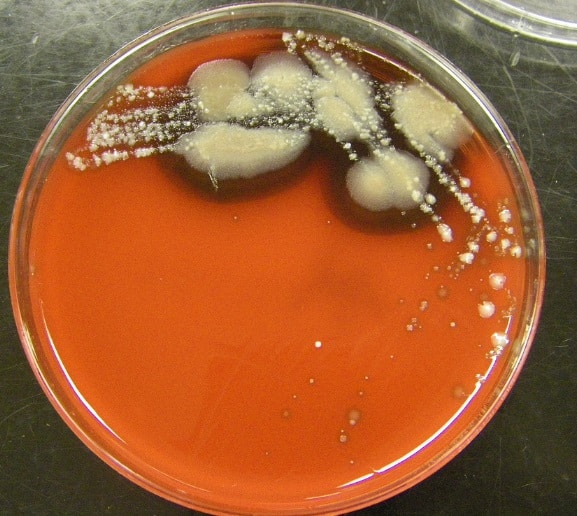
колонии гриба кандида

Симптоматика
Кандидоз желудка встречается довольно часто, однако диагностика этого состояния может вызывать трудности у врачей. Это связано с тем, что на ранних стадиях и при легком течении заболевание может не проявляться. Кроме того, отсутствуют специфические симптомы, которые могли бы указать на наличие микоза. Поэтому важно проводить тщательную дифференциальную диагностику с другими заболеваниями желудочно-кишечного тракта.
При микозе желудка могут наблюдаться следующие симптомы:
- Уменьшение аппетита, иногда сопровождающееся изменением вкусовых ощущений и трудностями при глотании, что происходит, когда грибок проникает в гортань;
- Рвота с характерными белыми прожилками, пленками и творожистыми образованиями – это один из наиболее ярких признаков кандидоза ЖКТ, хотя иногда тошнота может отсутствовать;
- В некоторых случаях возникает диарея, в стуле могут быть обнаружены творожистые выделения и следы слизи, что затрудняет дифференциацию с микозом кишечника;
- Боли в области желудка, в верхней части живота, которые могут быть как выраженными, так и слабо выраженными, напоминающими боли при гастрите (как эрозивном, так и катаральном);
- В редких случаях может развиваться системная симптоматика – вялость, слабость, сонливость, быстрая утомляемость, иногда даже незначительная лихорадка;
- В редких ситуациях микоз может сочетаться со стоматитом – поражением слизистых оболочек рта.
Как видно из описанных симптомов, их трудно отличить от признаков отравления, гастрита или язвы. Именно поэтому пациенты иногда долго не обращаются к врачу, пытаясь лечить гастрит привычными методами. Поскольку такая терапия оказывается неэффективной, но временно облегчает симптомы, заболевание может прогрессировать, так как колонии грибка продолжают беспрепятственно размножаться.
Это представляет собой серьезную опасность, так как кандидоз ЖКТ может перейти в генерализованную форму и начать поражать другие органы – пищевод, кишечник, гортань и так далее. При отсутствии лечения может произойти прободение стенок желудка и развитие перитонита.
В менее тяжелых случаях может происходить поражение сосудов, что приводит к небольшим, но неопасным кровотечениям, способным вызвать анемию. Теоретически грибки могут затрагивать мышечную ткань и провоцировать гастрит или язвенную болезнь.
Кандидоз желудка, по мнению врачей, представляет собой грибковую инфекцию, вызванную избыточным размножением грибов рода Candida. Развитие заболевания часто связано с ослаблением иммунной системы, длительным приемом антибиотиков или неправильным питанием. Врачи отмечают, что симптомы кандидоза могут варьироваться от легкого дискомфорта и вздутия до более серьезных проявлений, таких как тошнота, рвота и боли в животе. Важно, что заболевание может быть трудно диагностировать, так как его симптомы часто схожи с другими гастроэнтерологическими расстройствами. Специалисты подчеркивают необходимость комплексного подхода к лечению, включая применение противогрибковых препаратов и коррекцию рациона. Профилактика также играет ключевую роль, и врачи рекомендуют поддерживать здоровый образ жизни и избегать факторов, способствующих развитию инфекции.

Лечение
При подозрении на кандидоз желудка важно обратиться к гастроэнтерологу. Этот врач разработает план лечения, который будет включать различные подходы, а также специальный рацион, способствующий более быстрому выздоровлению. Назначение медикаментов основывается на понимании причин и видов грибков, вызвавших микоз.
Наиболее действенным средством считается Флуконазол и его аналоги, которые содержат то же активное вещество. Обычно его назначают в дозировке 100-150 мг, в зависимости от характера заболевания и индивидуальных особенностей пациента. Препарат принимается дважды в день.
В некоторых случаях курс лечения может длиться всего один день. Однако при более тяжелых формах может потребоваться повторный прием через 24-48 часов. В сложных ситуациях препарат может быть назначен на короткий срок. В большинстве случаев, при стандартном течении болезни, такого лечения оказывается достаточно.
Если кандидоз желудочно-кишечного тракта протекает с осложнениями или плохо поддается терапии из-за устойчивости грибка, могут быть назначены и другие медикаменты:
- Микогептин – противомикозный антибиотик, который принимается по две капсулы дважды в день после еды. Длительность лечения составляет две недели;
- Нистатин часто назначается при поражении всего ЖКТ, включая кишечник. Рекомендуется принимать 1-2 таблетки четыре раза в день;
- Леворин – еще одно эффективное противогрибковое средство, особенно при распространении инфекции на пищевод. Обычно назначается по 1 таблетке три раза в день, а продолжительность курса определяет врач в зависимости от степени поражения.
При тяжелых и запущенных формах заболевания пациенту может потребоваться стационарное лечение. В случае неосложненного течения болезни достаточно амбулаторной терапии и соблюдения низкоуглеводной диеты.
Кандидоз желудка — это грибковая инфекция, вызванная избыточным размножением грибов рода Candida. Люди, сталкивающиеся с этой проблемой, часто отмечают симптомы, такие как дискомфорт в области живота, вздутие, тошноту и даже рвоту. Многие пациенты сообщают о том, что кандидоз может развиваться на фоне ослабленного иммунитета, длительного приема антибиотиков или неправильного питания. Важно отметить, что диагностика может быть затруднена, так как симптомы часто схожи с другими заболеваниями желудочно-кишечного тракта. Некоторые эксперты подчеркивают, что для успешного лечения необходимо не только применение противогрибковых препаратов, но и изменение образа жизни, включая диету и укрепление иммунной системы. Люди, прошедшие лечение, отмечают улучшение состояния и возвращение к нормальному образу жизни, что подтверждает важность своевременной диагностики и комплексного подхода к терапии.
| Стадия развития | Симптомы | Диагностика |
|---|---|---|
| Начальная стадия (колонизация) | Часто бессимптомно или неспецифические симптомы: легкий дискомфорт в эпигастрии, изжога, отрыжка, вздутие живота. | Эндоскопия с биопсией (может быть нормальной или показывать легкое воспаление), анализ кала на дисбактериоз (может выявить избыток Candida), ПЦР-диагностика. |
| Активная стадия (инвазия) | Усиление симптомов: постоянная боль в эпигастрии (жгучая, ноющая), тошнота, рвота (иногда с примесью белых хлопьев), снижение аппетита, потеря веса, диарея или запоры, общая слабость, лихорадка (редко). | Эндоскопия с биопсией (обнаруживаются белые налеты, эрозии, язвы, псевдомембраны, гистологически подтверждается инвазия грибка), посев биоптата на грибы с определением чувствительности к антимикотикам, серологические тесты (определение антител к Candida). |
| Хроническая стадия (персистенция) | Симптомы могут быть менее выраженными, но постоянными: периодические боли, диспепсические явления, метеоризм, нарушения стула. Возможны рецидивы обострений. | Эндоскопия (может показывать атрофические изменения слизистой, рубцы, хроническое воспаление), повторные посевы на грибы, контроль эффективности лечения. |
| Осложнения | Желудочно-кишечное кровотечение (при эрозиях и язвах), перфорация желудка (редко), распространение инфекции на другие органы (системный кандидоз), формирование стриктур. | Эндоскопия, рентгенография с контрастированием, КТ, МРТ (для выявления осложнений и распространения инфекции). |
Видео

Вопрос-ответ
Как понять, что в желудке кандидоз?
Кандидоз в желудке может проявляться симптомами, такими как боль или дискомфорт в животе, тошнота, рвота, потеря аппетита и вздутие. Однако для точной диагностики необходимо обратиться к врачу, который может назначить эндоскопию или другие исследования для подтверждения наличия грибковой инфекции.

Как понять, что у тебя кандидоз пищевода?
Ощущение боли появляется в области за грудиной и обуславливается приемом пищи. Этот симптом кандидоза пищевода является следствием воспалительного процесса, вызванного активностью грибков в пищеводе. Боль может усиливаться, но обычно ее интенсивность не меняется. Изжога и отрыжка с неприятным запахом.
Как убрать кандидоз в желудке?
Для устранения симптомов используют азольные антимикотики («Итраконазол», «Кетоконазол», «Флуконазол»). Они активно всасываются из кишечника и оказывают выраженное системное действие. Терапию обычно начинают с введения «Амфотерицина В», а позже переходят на использование «Флуконазола».
Советы
СОВЕТ №1
Регулярно проходите медицинские обследования. Если у вас есть предрасположенность к кандидозу или вы замечаете симптомы, такие как боль в животе или дискомфорт после еды, не откладывайте визит к врачу. Ранняя диагностика поможет избежать осложнений.
СОВЕТ №2
Обратите внимание на свое питание. Избегайте избыточного потребления сахара и углеводов, так как они способствуют росту грибка Candida. Включите в рацион больше овощей, белков и пробиотиков, которые поддерживают здоровье кишечной флоры.
СОВЕТ №3
Управляйте стрессом. Хронический стресс может ослабить иммунную систему, что делает организм более уязвимым к инфекциям, включая кандидоз. Практикуйте методы релаксации, такие как медитация, йога или прогулки на свежем воздухе.
СОВЕТ №4
Следите за гигиеной. Соблюдение правил личной гигиены, особенно в области полости рта и желудочно-кишечного тракта, поможет предотвратить развитие кандидоза. Регулярная чистка зубов и использование антисептических средств могут снизить риск инфекции.